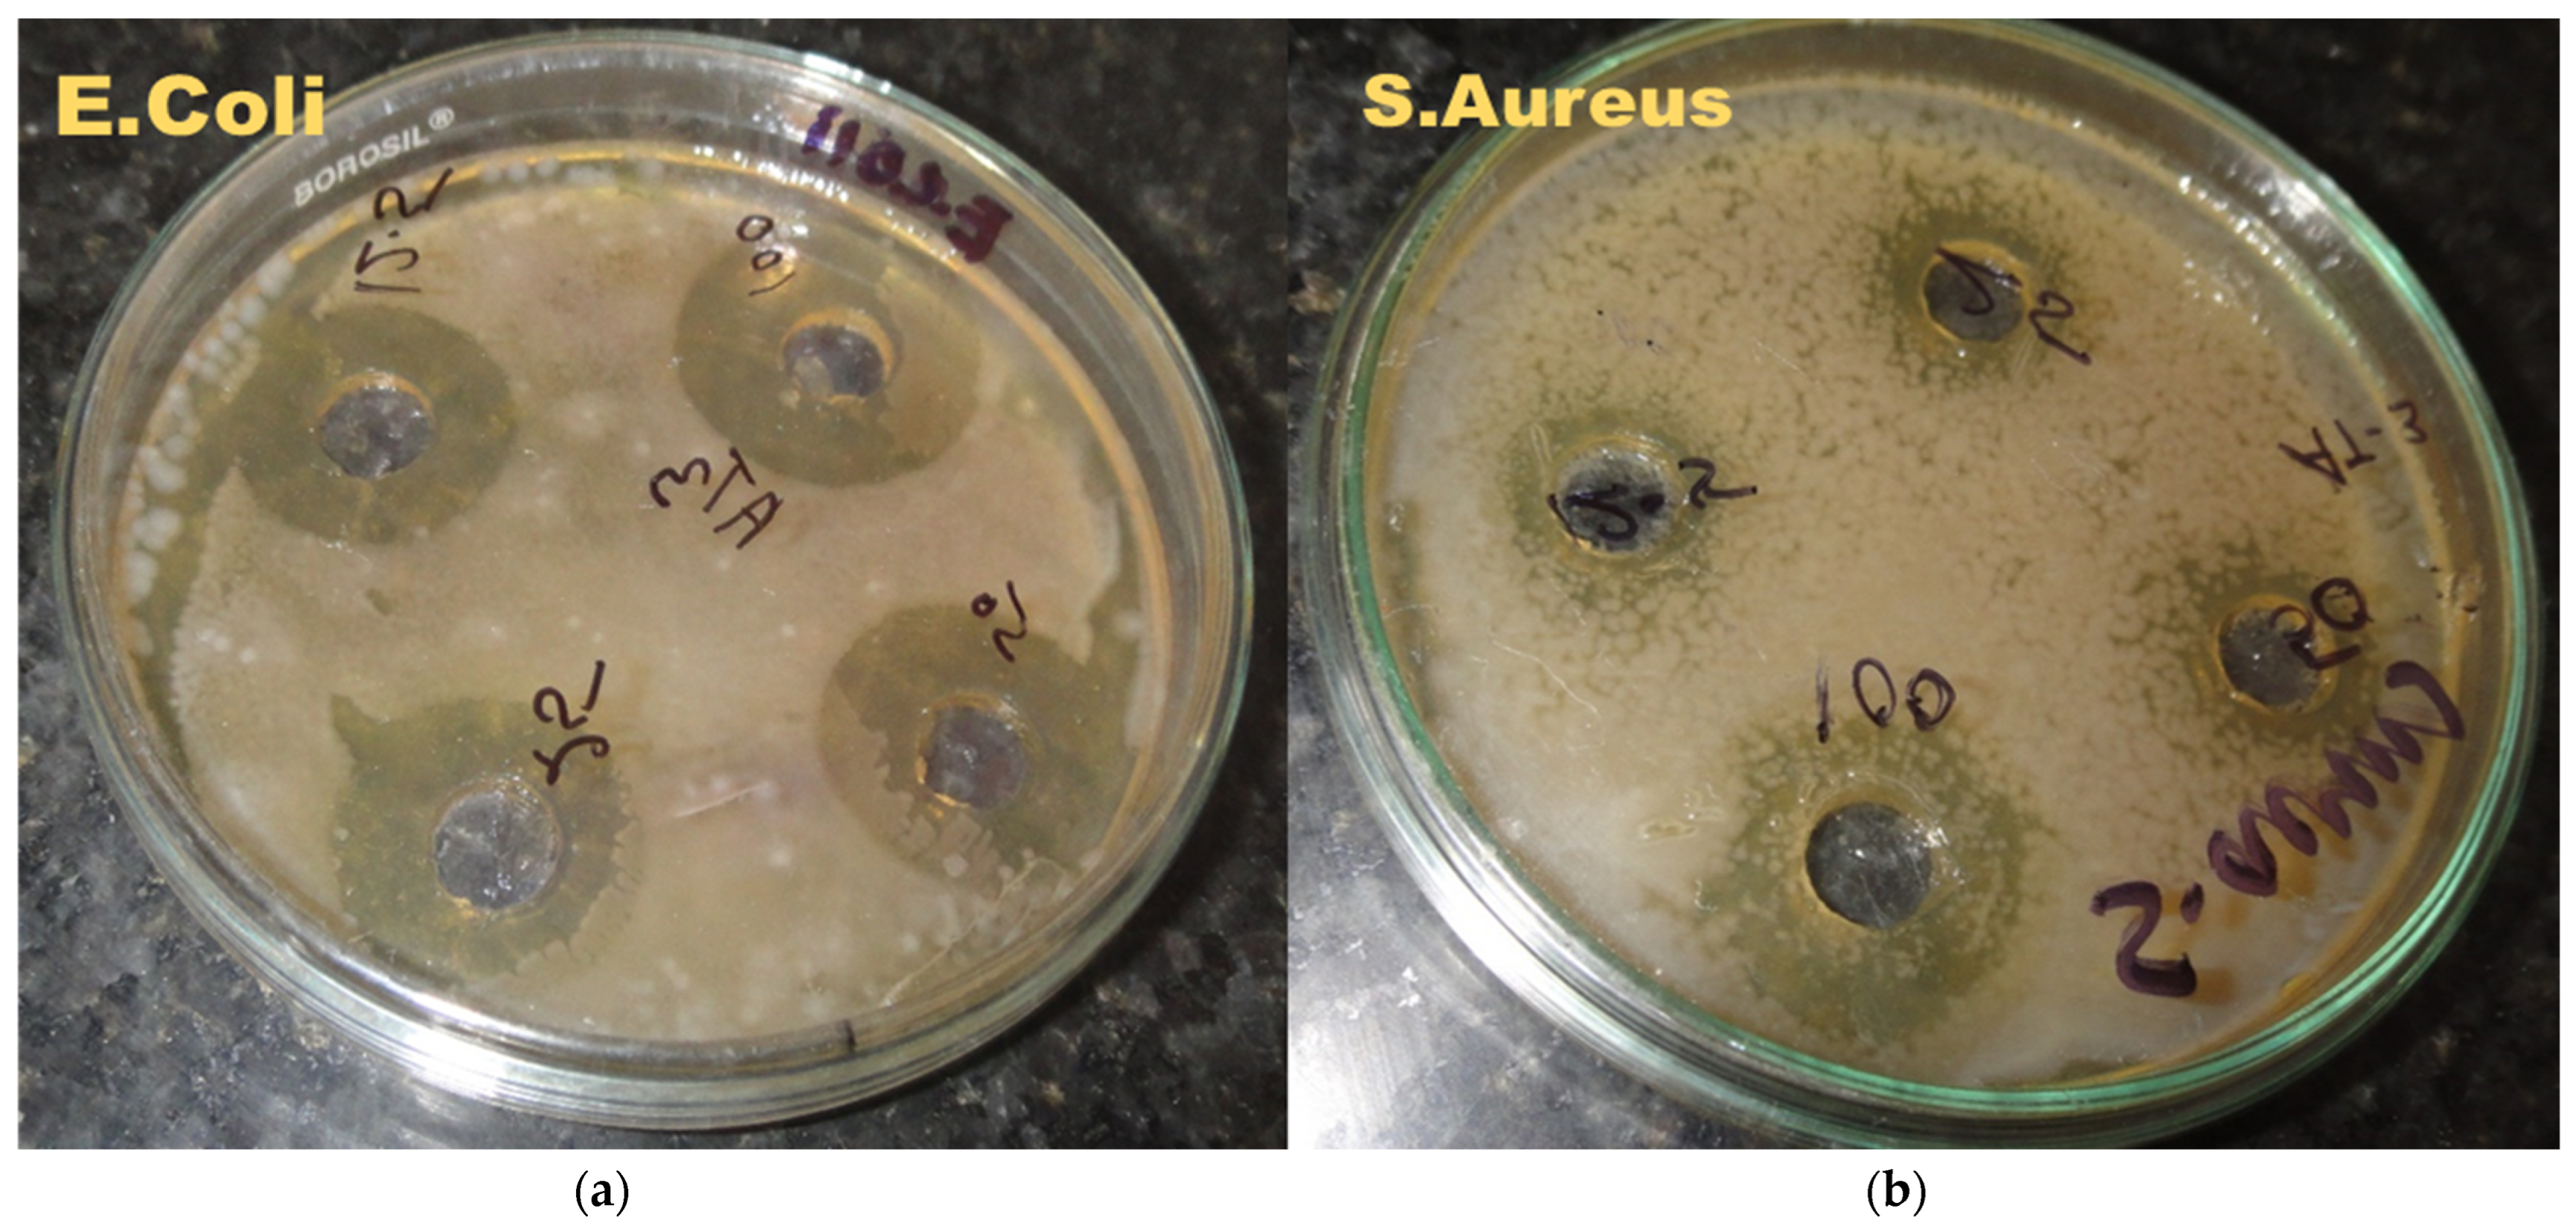
Ijms 24 02663 g005

Prospect of Bioactive Curcumin Nanoemulsion as Effective Agency to Improve Milk Based Soft Cheese by Using Ultrasound Encapsulation Approach
Abstract
1. Introduction
2. Results and Discussion
2.1. Characterization of Nanoemulsion
Particle Size Distribution, Polydispersity Index (PDI), and Optical Microscope for Stable Nanoemulsion
2.2. Transmission Electron Microscope Analysis of Nanoemulsion
2.3. Antimicrobial Activity Nanoemulsion
2.4. Curcumin Nanoemulsion in Cheese Formulation and Its Analysis
2.4.1. Sensory Analysis of Cheese
2.4.2. Physicochemical Parameters for Cheese
2.5. Scanning Electron Microscope Analysis of Cheese
2.6. Antioxidant Activity of Curcumin Nanoemulsion
3. Materials and Methods
3.1. Ultrasound Assisted Curcumin Encapsualtion
3.2. Physicochemical Analysis of Nanoemulsions
Nanoemulsion Stability
3.3. Transmission Electron Microscope (TEM) of Nanoemulsion Samples
3.4. Antimicrobial Activity of CuNE
3.5. Preparation of Cheese with Nanoemulsion
Physical and Chemical Analysis of Nanoemulsion-Enriched Cheese
3.6. Field Emission Scanning Electron Microscope of Cheese
3.7. Organoleptic Analysis of Cheese
3.8. Antioxidant of Processed Cheese
3.9. Statistical Analysis
4. Conclusions
Author Contributions
Funding
Institutional Review Board Statement
Informed Consent Statement
Data Availability Statement
Acknowledgments
Conflicts of Interest
References
- Mateos-Aparicio, I.; Matias, A. Food Industry Processing by-Products in Foods; Elsevier Inc.: Amsterdam, The Netherlands, 2019. [Google Scholar] [CrossRef]
- Talbot-Walsh, G.; Kannar, D.; Selomulya, C. A review on technological parameters and recent advances in the fortification of processed cheese. Trends Food Sci. Technol. 2018, 81, 193–202. [Google Scholar] [CrossRef]
- El-sayed, M.; Awad, S.; Ahmed, A.; El-sayed, I. The Effect of Storage Conditions on Physicochemical, Microbial and Textural Properties of UHT-Processed Cheese. Acta Sci. Nutr. Health 2020, 4, 76–85. [Google Scholar]
- Mohamed, A.; Shalaby, S. Texture, chemical properties and sensory evaluation of a spreadable processed cheese analogue made with apricot pulp (Prunus armeniaca L.). Int. J. Dairy Sci. 2016, 11, 61–68. [Google Scholar] [CrossRef]
- Mohamed, A.; Shalaby, S.; Gafour, W. Quality characteristics and acceptability of an analogue processed spreadable cheese made with carrot paste (Daucus carota L.). Int. J. Dairy Sci. 2016, 11, 91–99. [Google Scholar] [CrossRef]
- Mehanna, N.; Hassan, F.; El-Messery, T.; Mohamed, A. Production of functional processed cheese by using tomato juice. Int. J. Dairy Sci. 2017, 12, 155–160. [Google Scholar] [CrossRef]
- Přikryl, J.; Hájek, T.; Švecová, B.; Salek, R.; Černíková, M.; Červenka, L.; Buňka, F. Antioxidant properties and textural characteristics of processed cheese spreads enriched with rutin or quercetin: The effect of processing conditions. LWT 2018, 87, 266–271. [Google Scholar] [CrossRef]
- Aguilera-Garrido, A.; del Castillo-Santaella, T.; Galisteo-González, F.; Gálvez-Ruiz, M.J.; Maldonado-Valderrama, J. Investigating the role of hyaluronic acid in improving curcumin bioaccessibility from nanoemulsions. Food Chem. 2021, 351, 129301. [Google Scholar] [CrossRef]
- Páez-Hernández, G.; Mondragón-Cortez, P.; Espinosa-Andrews, H. Developing curcumin nanoemulsions by high-intensity methods: Impact of ultrasonication and microfluidization parameters. Lwt 2019, 111, 291–300. [Google Scholar] [CrossRef]
- Artiga-Artigas, M.; Lanjari-Pérez, Y.; Martín-Belloso, O. Curcumin-loaded nanoemulsions stability as affected by the nature and concentration of surfactant. Food Chem. 2018, 266, 466–474. [Google Scholar] [CrossRef]
- Jiang, T.; Liao, W.; Charcosset, C. Recent advances in encapsulation of curcumin in nanoemulsions: A review of encapsulation technologies, bioaccessibility and applications. Food Res. Int. 2020, 132, 109035. [Google Scholar] [CrossRef]
- Xu, W.; Huang, L.; Jin, W.; Ge, P.; Shah, B.; Zhu, D.; Jing, J. Encapsulation and release behavior of curcumin based on nanoemulsions-filled alginate hydrogel beads. Int. J. Biol. Macromol. 2019, 134, 210–215. [Google Scholar] [CrossRef] [PubMed]
- Hong, S.; Garcia, C.V.; Park, S.; Shin, G.; Kim, J. Retardation of curcumin degradation under various storage conditions via turmeric extract-loaded nanoemulsion system. Lwt 2019, 100, 175–182. [Google Scholar] [CrossRef]
- Qazi, H.; Ye, A.; Acevedo-Fani, A.; Singh, H. In vitro digestion of curcumin-nanoemulsion-enriched dairy protein matrices: Impact of the type of gel structure on the bioaccessibility of curcumin. Food Hydrocoll. 2021, 117, 106692. [Google Scholar] [CrossRef]
- Bagale, U.; Tsaturov, A.; Potoroko, I.; Potdar, S.; Sonawane, S. In-vitro evaluation of high dosage of curcumin encapsulation in palm-oil-in-water, nanoemulsion stabilized with a sonochemical approach. Karbala Int. J. Mod. Sci. 2022, 8, 83–95. [Google Scholar] [CrossRef]
- Schneider, C.; Gordon, O.; Edwards, R.; Luis, P. Degradation of Curcumin: From Mechanism to Biological Implications. J. Agric. Food Chem. 2015, 63, 7606–7614. [Google Scholar] [CrossRef]
- Moghaddasi, F.; Housaindokht, M.; Darroudi, M.; Bozorgmehr, M.; Sadeghi, A. Soybean oil-based nanoemulsion systems in absence and presence of curcumin: Molecular dynamics simulation approach. J. Mol. Liq. 2018, 264, 242–252. [Google Scholar] [CrossRef]
- Mošovská, S.; Petáková, P.; Kaliňák, M.; Mikulajová, A. Antioxidant properties of curcuminoids isolated from Curcuma longa L. Acta Chim. Slovaca. 2016, 9, 130–135. [Google Scholar] [CrossRef]
- Luo, X.; Zhou, Y.; Bai, L.; Liu, F.; Deng, Y.; McClements, D. Fabrication of β-carotene nanoemulsion-based delivery systems using dual-channel microfluidization: Physical and chemical stability. J. Colloid Interface Sci. 2017, 490, 328–335. [Google Scholar] [CrossRef]
- Biswas, A.; Islam, M.; Choudhury, Z.; Mostafa, A.; Kadir, M. Nanotechnology based approaches in cancer therapeutics. Adv. Nat. Sci. Nanosci. Nanotechnol. 2014, 5, 043001. [Google Scholar] [CrossRef]
- Rajasekar, A.; Devasena, T. Facile synthesis of Curcumin nanocrystals and validation of its antioxidant activity against circulatory toxicity in wistar rats. J. Nanosci. Nanotechnol. 2015, 15, 4119–4125. [Google Scholar] [CrossRef]
- Moghaddasi, F.; Housaindokht, M.; Darroudi, M.; Bozorgmehr, M.; Sadeghi, A. Synthesis of nano curcumin using black pepper oil by O/W Nanoemulsion Technique and investigation of their biological activities. LWT 2018, 92, 92–100. [Google Scholar] [CrossRef]
- Robles-García, M.; Rodríguez-Félix, F.; Márquez-Ríos, E.; Aguilar, J.; Barrera-Rodríguez, A.; Aguilar, J.; Ruiz-Cruz, S.; Del-Toro-Sánchez, C. Applications of nanotechnology in the agriculture, food, and pharmaceuticals. J. Nanosci. Nanotechnol. 2016, 16, 8188–8207. [Google Scholar] [CrossRef]
- Lu, W.; Huang, D.; Wang, C.; Yeh, C.; Tsai, J.; Huang, Y.; Li, P. Preparation, characterization, and antimicrobial activity of nanoemulsions incorporating citral essential oil. J. Food Drug Anal. 2018, 26, 82–89. [Google Scholar] [CrossRef] [PubMed]
- de Cenobio-Galindo, A.J.; Campos-Montiel, R.; Jiménez-Alvarado, R.; Almaraz-Buendía, I.; Medina-Pérez, G.; Fernández-Luqueno, F. Development and incorporation of nanoemulsions in food. Int. J. Food Stud. 2019, 8, 105–124. [Google Scholar] [CrossRef]
- Rezaei, A.; Fathi, M.; Jafari, S. Nanoencapsulation of hydrophobic and low-soluble food bioactive compounds within different nanocarriers. Food Hydrocoll. 2019, 88, 146–162. [Google Scholar] [CrossRef]
- Solans, C.; Solé, I. Nano-emulsions: Formation by low-energy methods. Curr. Opin. Colloid Interface Sci. 2012, 17, 246–254. [Google Scholar] [CrossRef]
- Kumar, D.; Mann, B.; Pothuraju, R.; Sharma, R.; Bajaj, R. Minaxi, Formulation and characterization of nanoencapsulated curcumin using sodium caseinate and its incorporation in ice cream. Food Funct. 2016, 7, 417–424. [Google Scholar] [CrossRef] [PubMed]
- Negahdari, R.; Ghavimi, M.A.; Barzegar, A.; Memar, M.Y.; Balazadeh, L.; Bohlouli, S.; Maleki Dizaj, S. Antibacterial effect of nanocurcumin inside the implant fixture: An in vitro study. Clin. Exp. Dent. Res. 2020, 7, 163–169. [Google Scholar] [CrossRef] [PubMed]
- Wang, L.; Hu, C.; Shao, L. The antimicrobial activity of nanoparticles: Present situation and prospects for the future. Int. J. Nanomed. 2017, 12, 1227. [Google Scholar] [CrossRef]
- Moncada, M.; Astete, C.; Sabliov, C.; Olson, D.; Boeneke, C.; Aryana, K. Nano spray-dried sodium chloride and its effects on the microbiological and sensory characteristics of surface-salted cheese crackers. J. Dairy Sci. 2015, 98, 5946–5954. [Google Scholar] [CrossRef]
- Salminen, H.; Ankenbrand, J.; Zeeb, B.; Bönisch, G.B.; Schäfer, C.; Kohlus, R.; Weiss, J. Influence of spray drying on the stability of food-grade solid lipid nanoparticles. Food Res. Int. 2019, 119, 741–750. [Google Scholar] [CrossRef] [PubMed]
- Yusop, S.; O’Sullivan, M.; Preuß, M.; Weber, H.; Kerry, J.; Kerry, J. Assessment of nanoparticle paprika oleoresin on marinating performance and sensory acceptance of poultry meat. LWT—Food Sci. Technol. 2012, 46, 349–355. [Google Scholar] [CrossRef]
- El-Sayed, M.I.; Shalaby, T.I. Production of Processed Cheese Supplemented with Curcumin Nanoemulsion. Am. J. Food Nutr. 2021, 9, 96–105. [Google Scholar] [CrossRef]
- Kadi, A.; Bagale, U.; Potoroko, I. The effect of ultrasonic processing on physical and chemical properties of milk-based soft, brine cheese. Indones. J. Biotechnol. 2022, 27, 219–226. [Google Scholar] [CrossRef]
- Surassmo, S.; Min, S.; Bejrapha, P.; Choi, M. Effects of surfactants on the physical properties of capsicum oleoresin-loaded nanocapsules formulated through the emulsion-diffusion method. Food Res. Int. 2010, 43, 8–17. [Google Scholar] [CrossRef]
- Sahingil, D.; Hayaloglu, A.; Simsek, O.; Ozer, B. Changes in volatile composition, proteolysis and textural and sensory properties of white-brined cheese: Effects of ripening temperature and adjunct culture. Dairy Sci. Technol. 2014, 94, 603–623. [Google Scholar] [CrossRef]
- Shabbir, M.; Ahmed, H.; Maan, A.; Rehman, A.; Afraz, M.; Iqbal, M.; Khan, I.; Amir, R.; Ashraf, W.; Khan, M.; et al. Effect of non-thermal processing techniques on pathogenic and spoilage microorganisms of milk and milk products. Food Sci. Technol. 2021, 41, 279–294. [Google Scholar] [CrossRef]

| Exp No | pH | Gravitational Stability at Room Temperature(Days) | Particle Size for Fresh Sample (nm) | Particle Size after 60 Days (nm) | PDI | Zeta Potential mV | Encapsulation Efficiency |
|---|---|---|---|---|---|---|---|
| CUNE 1 | 5.68 | 15 | 180 ± 0.5 | 820 ± 5 | 0.63 | −15 | 94% |
| CUNE 2 | 5.62 | 70 | 13.35 ± 0.5 | 14.05 ± 0.5 | 0.27 | −25 | |
| CUNE 3 | 5.69 | 75 | 11.05 ± 0.5 | 12 ± 05 | 0.35 | −27 | |
| CUNE 4 | 5.55 | 15 | 135 ± 3 | 625 ±10 | 0.43 | −18 |
| Microorganism | Zone Inhibition Diameter (mm) | |||
|---|---|---|---|---|
| 100 * | 50 * | 25 * | 12.5 * | |
| E. Coli | 18 | 15 | 13 | 8.2 |
| S. Aureus | 12 | 9 | 6 | 3 |
| Storage Time | Ash,% | Dry Matter,% | pH | Protein,% | Fat,% | |
|---|---|---|---|---|---|---|
| Control | Fresh | 5.53 ± 0.13 | 39.46 ± 0.34 | 6.2 ± 0.08 | 12.12 ± 0.08 | 18.85 ± 0.27 |
| 30 days | 5.98 ± 0.14 | 42.34 ± 0.11 | 6.04 ± 0.04 | 12.66 ± 0.09 | 19.65 ± 0.2 | |
| 60 days | 6.01 ± 0.1 | 43.24 ± 0.15 | 6.01 ± 0.06 | 12.91 ± 0.12 | 20.71 ± 0.13 | |
| E1 (Cur) | Fresh | 5.66 ± 0.11 | 39.28 ± 0.33 | 6.19 ± 0.08 | 12.63 ± 0.36 | 18.68 ± 0.23 |
| 30 days | 5.71 ± 0.14 | 40.53 ± 0.11 | 6.05 ± 0.04 | 12.6 ± 0.09 | 18.93 ± 0.38 | |
| 60 days | 5.75 ± 0.08 | 41.72 ± 0.22 | 6.03 ± 0.03 | 12.68 ± 0.09 | 19.14 ± 0.12 | |
| E2 | Fresh | 5.61 ± 0.38 | 39.14 ± 0.57 | 6.21 ± 0.08 | 11.72 ± 0.15 | 18.97 ± 0.27 |
| 30 days | 5.64 ± 0.07 | 41.41 ± 0.48 | 6.1 ± 0.01 | 11.7 ± 0.17 | 19.23 ± 0.21 | |
| 60 days | 5.69 ± 0.09 | 41.84 ± 0.22 | 6.04 ± 0.05 | 11.74 ± 0.14 | 19.41 ± 0.12 |
| Specimen | AOA Prototypes Crumb mg |
|---|---|
| The control | 0.1059 ± 0.05 |
| Sample 1 (CUNE) | 0.3164 ± 0.015 |
| Sample 2 (Emulsion) | 0.0829 ± 0.02 |
Disclaimer/Publisher’s Note: The statements, opinions and data contained in all publications are solely those of the individual author(s) and contributor(s) and not of MDPI and/or the editor(s). MDPI and/or the editor(s) disclaim responsibility for any injury to people or property resulting from any ideas, methods, instructions or products referred to in the content. |
© 2023 by the authors. Licensee MDPI, Basel, Switzerland. This article is an open access article distributed under the terms and conditions of the Creative Commons Attribution (CC BY) license (https://creativecommons.org/licenses/by/4.0/).
Share and Cite
Bagale, U.; Kadi, A.; Abotaleb, M.; Potoroko, I.; Sonawane, S.H. Prospect of Bioactive Curcumin Nanoemulsion as Effective Agency to Improve Milk Based Soft Cheese by Using Ultrasound Encapsulation Approach. Int. J. Mol. Sci. 2023, 24, 2663. https://doi.org/10.3390/ijms24032663
Bagale U, Kadi A, Abotaleb M, Potoroko I, Sonawane SH. Prospect of Bioactive Curcumin Nanoemulsion as Effective Agency to Improve Milk Based Soft Cheese by Using Ultrasound Encapsulation Approach. International Journal of Molecular Sciences. 2023; 24(3):2663. https://doi.org/10.3390/ijms24032663
Chicago/Turabian StyleBagale, Uday, Ammar Kadi, Mostafa Abotaleb, Irina Potoroko, and Shirish Hari Sonawane. 2023. "Prospect of Bioactive Curcumin Nanoemulsion as Effective Agency to Improve Milk Based Soft Cheese by Using Ultrasound Encapsulation Approach" International Journal of Molecular Sciences 24, no. 3: 2663. https://doi.org/10.3390/ijms24032663
APA StyleBagale, U., Kadi, A., Abotaleb, M., Potoroko, I., & Sonawane, S. H. (2023). Prospect of Bioactive Curcumin Nanoemulsion as Effective Agency to Improve Milk Based Soft Cheese by Using Ultrasound Encapsulation Approach. International Journal of Molecular Sciences, 24(3), 2663. https://doi.org/10.3390/ijms24032663

